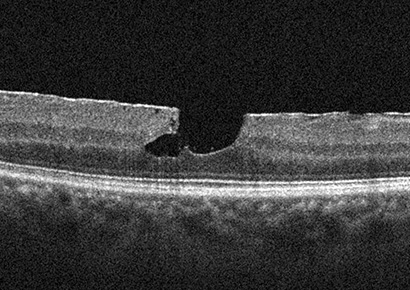
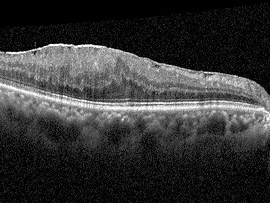
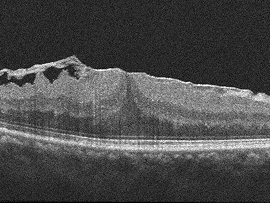

망막전막이란?
망막전막은 중심부 망막 위에 얇은 막이 형성되어 망막을 잡아당기거나 주름지게 하는 질환입니다.
주로 50세 이후에 발생하며, 노화, 당뇨망막병증 같은 망막의 혈관질환, 안내 수술이나 염증을 앓은 이후에 생기기도 합니다.

주요 증상




망막전막 주요 증상
초기에는 증상이 경미할 수 있으나, 진행된 경우 일상생활에 큰 불편을 줄 수 있습니다.
진단
정밀안저검사 및 빛간섭단층촬영 등을 통해 망막 위에 덮인 막의 크기와 두께, 망막의 구조 변화를 정밀하게 확인합니다.

치료 방법
1. 경미한 경우
- 변형시나 시력 저하가 크지 않으면 정기적으로 경과를 확인합니다.
2. 심한 경우
수술 전
수술 전
 수술 후
수술 후- 수술적 치료(유리체절제술 및 막제거술)를 통해 망막전막을 제거합니다.
- 수술 후 대부분 시력 개선과 함께 변형시가 완화되지만, 회복 정도는 수술 전 망막전막의 상태와 환자의 전신 상태에 따라 달라질 수 있습니다.
왜 모두다연세안과일까?
대학병원에서 오랜 기간 수많은 환자들을 진료하고 수술한 경험과 학술적 지식을 바탕으로 최선의 판단을 도와드리고,
수술 전후 체계적인 맞춤 관리를 통해 망막전막 환자분들의 시력과 삶의 질을 지켜드리고 있습니다.










